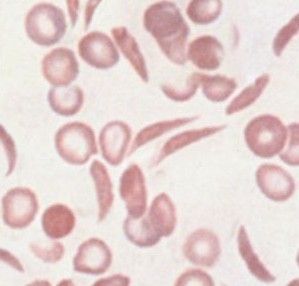
鐮狀細胞貧血病

發現
鐮狀細胞貧血鐮狀細胞貧血病主要見於非洲黑人。雜合子狀態者占非洲黑人的20%,美國黑人群的8%,此外也見於中東、希臘、土籍印第安人及與上述民族長期通婚的人群。雜合子之間通婚,其1/4 子女為純合子,導致鐮狀細胞貧血病。
體徵
患者出生半年後,症狀和體徵逐漸出現。由於早年發病,患者多有生長和發育不良,一般狀況較差,易發生感染,尤其是肺炎球菌性感染,此與勞累、脾功能受損有關。有貧血、黃疸和肝、脾大,心、肺功能常受損,可發生充血性心力衰竭。
腎臟受累可表現為等滲尿、血尿、多尿,部分患者發展為腎病綜合徵、腎功能衰竭。骨質疏鬆,導致脊柱變形呈雙凹形或魚嘴形,股骨頭無菌性壞死,而另一方面,骨骼梗死又可導致骨小梁增加和骨質硬化。
眼部症狀由視網膜梗死、眼底出血、視網膜脫離等病變引起。神經系統表現有腦血栓形成、蛛網膜下隙出血。男性患者可有性功能不全。下肢皮膚慢性潰瘍是常見的體徵。
危害
患有鐮狀細胞貧血病的人,紅血球會出現嚴重的扭曲。因此,病變會阻礙血液流通,進而會導致慢性疼痛、感染和組織壞死等問題。
鐮狀細胞貧血病威脅生命的複雜化可以是突然和嚴厲的貧血症。正常紅血球這嚴厲短缺也許導致弱點、呼吸淺短,甚至心力衰竭。心力衰竭造成的震動的症狀是低血壓、迅速脈衝和越來越少的知覺。
併發症
1、梗死型危象:系最常見的一種危象,鐮變的僵硬紅細胞阻塞小血管;組織缺氧,重者導致組織壞死。
2、再生障礙型危象:貧血突然加重,網織紅細胞顯著減少甚或消失,骨髓增生低下。感染尤其是微小病毒感染是常見誘發因素。
3、巨幼細胞型危象:妊娠患者易發生此型危象,葉酸缺乏是主要原因。嚴重貧血伴有巨幼細胞貧血特徵是本型的主要臨床表現。
4、脾滯留型危象:此型危象多見於兒童患者,也可見於脾顯著增大的成年患者。主要臨床表現是血紅蛋白的濃度陡然下降。在幼年患兒可成為致死原因。
5、溶血型危象:此型危象不常見。當本病患者合併其他疾患(如G6PD 缺乏)時,易發生溶血危象。臨床表現為貧血加重、黃疸、網織紅細胞數增多。常發生溶血者易有膽石症。
診斷檢查
“鐮狀細胞貧血病”的細胞組織本病的診斷並不困難,重要的是要考慮到本病的可能性而不遺漏本病。根據種族和家族史、鐮變試驗陽性、血紅蛋白電泳顯示主要成分為HbS,再結合臨床表現,即可明確診斷。
實驗室檢查
1、外周血:血紅蛋白為50—100g/L,危象時進一步降低。網織紅細胞計數常在10%以上。紅細胞大小不均,多染性、嗜鹼性點彩細胞增多,可見有核紅細胞、靶形紅細胞、異形紅細胞、Howell-Jolly 小體。鐮狀紅細胞並不多見,若發現則有助於診斷。通常採用“鐮變試驗”檢查有無鐮狀細胞。紅細胞滲透脆性顯著降低。白細胞和血小板計數一般正常。
2、骨髓象:示紅系顯著增生,但在再生障礙危象時增生低下,在巨幼細胞危象時有巨幼細胞變。
3、血清膽紅素:輕—中度增高,溶血危象時顯著增高。本病的溶血雖以血管外溶血為主,但也存在著血管內溶血。
4、血漿結合珠蛋白:降低,血漿游離血紅蛋白可能增高。
5、紅細胞半衰期測定:顯示紅細胞生存時間明顯縮短至5—15 天[正常為(28±5)天]。
6、血紅蛋白電泳:顯示HbS 占80%以上,HbF 增多至2%—15%,HbA2 正常,而HbA 缺如。
其他輔助檢查
根據病情、臨床表現、症狀、體徵選擇做心電圖、X 線、CT、MRI、B 超、生化等檢查。
治療
至2010年,該症尚缺乏有效治療辦法。患者大都已經適應慢性貧血,若非必需,不宜經常輸血,因為輸血有提高血細胞比容、增加血液黏滯度而引發血管堵塞的危險,反覆輸血還有增加感染機會和引起繼發性血色病的發生。
當發生再生障礙型危象時,應予輸紅細胞。發生巨幼細胞危象時,應予葉酸(10—15mg/d)治療。一旦發生梗死危象、溶血危象或其他嚴重臨床情況(如嚴重感染、重度下肢潰瘍、患者需行全身麻醉和手術)時,可進行換血療法,輸入洗滌紅細胞並補充右鏇糖酐40(低分子右鏇糖酐)或5%葡萄糖水,目的是使含HbS 的紅細胞減少至25%—50%以下,維持血液循環暢通。
給予氧氣吸入有一定幫助。及早給予止痛劑減輕患者痛苦。本病患者易發生感染,感染又可誘發危象,故應注意預防和治療感染。脾切除對本病無明顯療效。同種異基因骨髓移植治療,套用羥基脲、紅細胞生成素並配合補鐵,可顯著提高HbF水平,減少栓塞危象和輸血量。
鐮狀細胞或可導致腫瘤細胞死亡
2013年新的研究發現,鐮狀細胞貧血的通常來說有害的特徵也有有益的用途:切斷癌性腫瘤的供血。來自美國杜克大學和Jenomic研究所的研究者開發了一種新方法:利用鐮刀狀紅血細胞選擇性地靶定小鼠的缺氧癌性腫瘤,並阻塞圍繞在腫瘤外的血管,從而導致腫瘤細胞的死亡 。
圖特卡蒙死因研究
長期以來,圖特卡蒙的死因引起了諸多猜測。2010年2月,德國漢堡伯尼哈特·諾查特熱帶醫學研究所的科學家們對埃及考古學家關於這位擁有謎一般身世的法老圖特卡蒙的死因的研究結論提出了質疑。此前,埃及考古學家首先對圖特卡蒙的木乃伊進行了科學檢測,如DNA檢測和CT掃描。通過檢測,埃及考古學家認為,圖特卡蒙在經受一次摔傷後最終死於瘧疾。這一理論推翻了圖特卡蒙被謀殺致死的說法。
但是,德國研究人員在《美國醫學會雜誌》線上刊物上發表文章稱,通過對圖特卡蒙足部骨骼更細緻的檢測,他們發現圖特卡蒙應該死於鐮狀細胞貧血病。
文章認為,“我們對埃及研究人員在他們的論文中所提供的基因數據的可靠性以及作者所得出的結論的正確性提出質疑。放射檢測的跡象與鐮狀細胞貧血病中所看到的骨質病變損害相一致。在埃及綠洲的居民中,有大約9%到22%的人攜帶這種致病基因,這種血液病變通常發生於攜帶這種基因的人身上。”